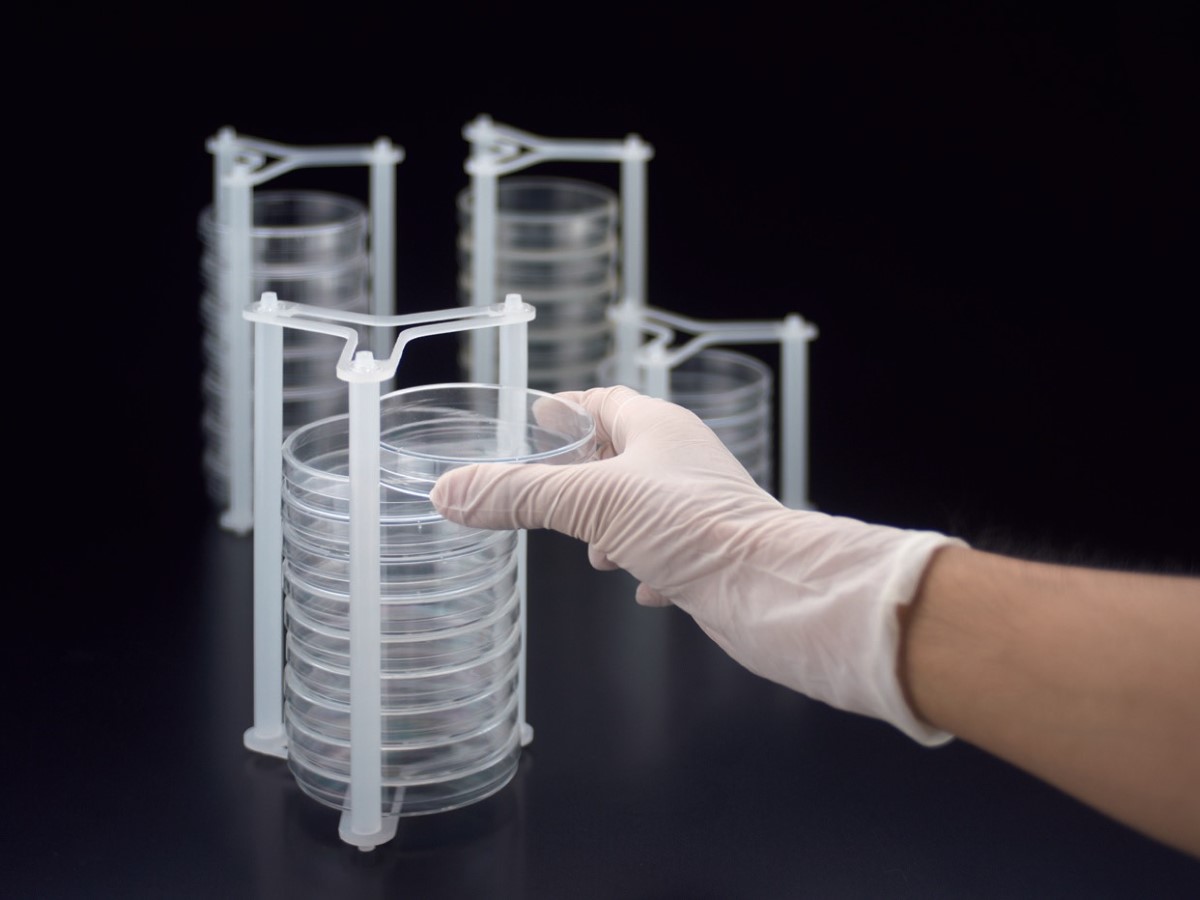

Sanplatec Petri dish Multi-rack (Petri Multi-rack)
Description
●This is a petri dish for agar media.
●This rack can be used for all operations, such as loading, unloading, inverting, opening and closing the lid, carrying, and storing petri dishes.
●The top surface is deformable to widen the gap between the columns.
●It easy to carry stacked petri dishes.
●The rack can be inverted to hold petri dishes stably while they are in the rack.
●In the case of bacterial culture, the entire rack can be stored in an incubator.
●Autoclavable.
●Designed to minimize dead space when stored in an incubator or on a shelf.
●Material/main body: PP, washer: polycarbonate.
Caution
Specifications
Catalog No.
Model
Main body O.D(mm)
Internal dimension (mm)
Bore(mm)
Body diameter×height(mm)
Spec 1
Spec 2
Spec 3
Spec 4
Shelf(pc)
Scale(mL)
Material
Weight(Kg)
Inquire about this product

One or more field is invalid!
Please check and try again.

Inquiry sent!
We’ll get back to you as soon as possible.